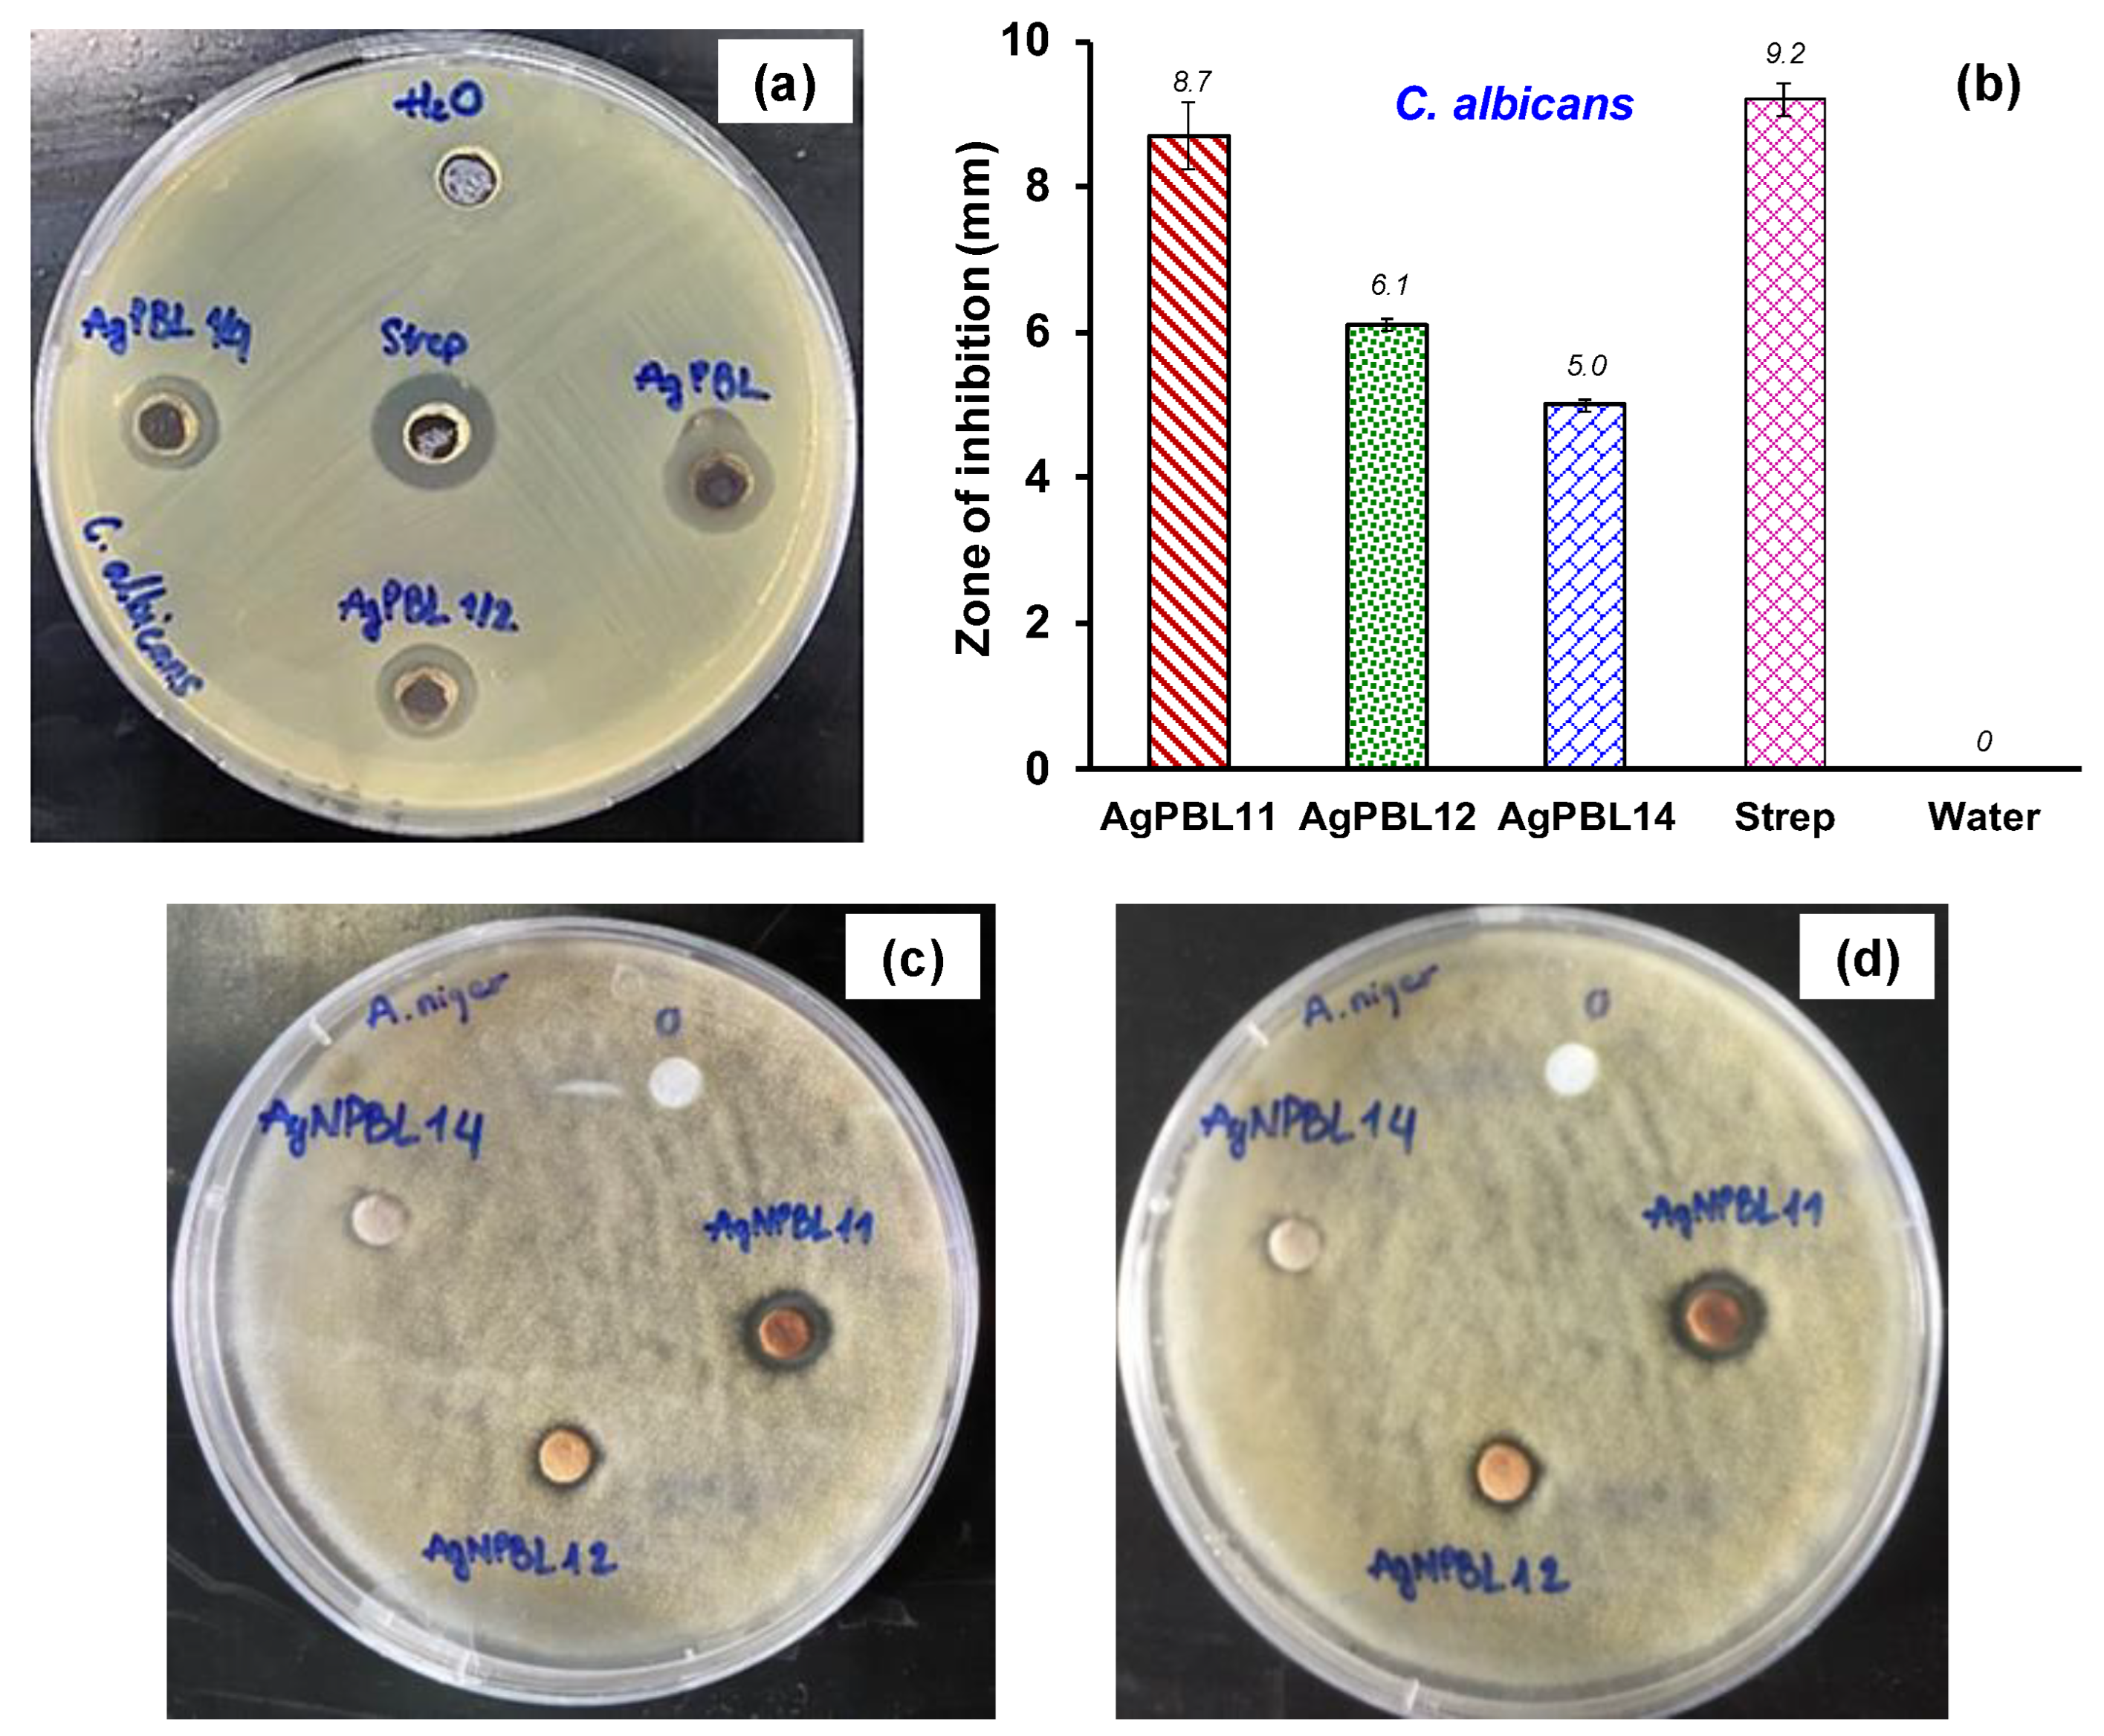
Polymers 15 02634 g003

Antibacterial and Antifungal Fabrication of Natural Lining Leather Using Bio-Synthesized Silver Nanoparticles from Piper Betle L. Leaf Extract
Abstract
1. Introduction
2. Materials and Methods
2.1. Materials
2.2. Synthesis and Application of AgPBL to Pig Lining Leather
2.3. Analytical Methods
2.3.1. Characterization of the AgPBL
2.3.2. Characterization of the Modified Pig Leather
2.3.3. Physico-Mechanical Characterization
2.4. Antibacterial and Antifungal Activities
2.4.1. Bio-Synthesized Silver Nanoparticles (AgPBL)
2.4.2. The Modified Pig Leather
3. Results and Discussion
3.1. Synthesis and Antimicrobial Activity of AgPBL
3.2. Coloration and Characteristics of the AgPBL-Modified Pig Leather
3.3. Antibacterial and Antifungal Efficacy of the AgPBL-Modified Pig Leather
3.3.1. Antibacterial Efficacy
3.3.2. Antifungal Efficacy
3.4. The Physico-Mechanical Properties of the AgPBL-Modified Pig Leather
4. Conclusions
Author Contributions
Funding
Institutional Review Board Statement
Data Availability Statement
Acknowledgments
Conflicts of Interest
References
- Bai, Z.; Wang, X.; Zheng, M.; Yue, O.; Xie, L.; Zha, S.; Dong, S.; Li, T.; Song, Y.; Huang, M.; et al. Leather for flexible multifunctional bio-based materials: A review. J. Leather Sci. Eng. 2022, 4, 16. [Google Scholar] [CrossRef]
- Xia, Q.; Yang, L.; Hu, K.; Li, K.; Xiang, J.; Liu, G.; Wang, Y. Chromium Cross-Linking Based Immobilization of Silver Nanoparticle Coating on Leather Surface with Broad-Spectrum Antimicrobial Activity and Durability. ACS Appl. Mater. Interface 2019, 11, 2352–2363. [Google Scholar] [CrossRef]
- Wu, X.; Wu, J.; Mu, C.; Wang, C.; Lin, W. Advances in Antimicrobial Polymer Coatings in the Leather Industry: A Comprehensive Review. Ind. Eng. Chem. Res. 2021, 60, 15004–15018. [Google Scholar] [CrossRef]
- Fan, Q.; Ma, J.; Xu, Q. Insights into functional polymer-based organic-inorganic nanocomposites as leather finishes. J. Leather Sci. Eng. 2019, 1, 3. [Google Scholar] [CrossRef]
- Liu, G.; Haiqi, G.; Li, K.; Xiang, J.; Lan, T.; Zhang, Z. Fabrication of silver nanoparticle sponge leather with durable antibacterial property. J. Colloid Interface Sci. 2018, 514, 338–348. [Google Scholar] [CrossRef]
- Lkhagvajav, N.; Koizhaiganova, M.; Yasa, I.; Çelik, E.; Sari, Ö. Characterization and antimicrobial performance of nano silver coatings on leather materials. Braz. J. Microbiol. 2015, 46, 41–48. [Google Scholar] [CrossRef]
- Sportelli, M.C.; Picca, R.A.; Paladini, F.; Mangone, A.; Giannossa, L.C.; Di Franco, C.; Gallo, A.L.; Valentini, A.; Sannino, A.; Pollini, M. Spectroscopic characterization and nanosafety of Ag-modified antibacterial leather and leatherette. Nanomaterials 2017, 7, 203. [Google Scholar] [CrossRef]
- Abou Elmaaty, T.; Sayed-Ahmed, K.; Mohamed Ali, R.; El-Khodary, K.; Abdeldayem, S.A. Simultaneous sonochemical coloration and antibacterial functionalization of leather with selenium nanoparticles (SeNPs). Polymers 2022, 14, 74. [Google Scholar] [CrossRef]
- Velmurugan, P.; Lee, S.-M.; Cho, M.; Park, J.-H.; Seo, S.-K.; Myung, H.; Bang, K.-S.; Oh, B.-T. Antibacterial activity of silver nanoparticle-coated fabric and leather against odor and skin infection causing bacteria. Appl. Microbiol. Biotechnol. 2014, 98, 8179–8189. [Google Scholar] [CrossRef]
- Elsayed, H.; Hasanin, M.; Rehan, M. Enhancement of multifunctional properties of leather surface decorated with silver nanoparticles (Ag NPs). J. Mol. Struct. 2021, 1234, 130130. [Google Scholar] [CrossRef]
- Xiang, J.; Ma, L.; Su, H.; Xiong, J.; Li, K.; Xia, Q.; Liu, G. Layer-by-layer assembly of antibacterial composite coating for leather with cross-link enhanced durability against laundry and abrasion. Appl. Surf. Sci. 2018, 458, 978–987. [Google Scholar] [CrossRef]
- Velmurugan, P.; Cho, M.; Lee, S.-M.; Park, J.-H.; Bae, S.; Oh, B.-T. Antimicrobial fabrication of cotton fabric and leather using green-synthesized nanosilver. Carbohydr. Polym. 2014, 106, 319–325. [Google Scholar] [CrossRef] [PubMed]
- Koizhaiganova, M.; Yaşa, I.; Gülümser, G. Assessment of antibacterial activity of lining leather treated with silver doped hydroxyapatite. Int. Biodeterior. Biodegrad. 2015, 105, 262–267. [Google Scholar] [CrossRef]
- Velmurugan, P.; Shim, J.; Bang, K.-S.; Oh, B.-T. Gold nanoparticles mediated coloring of fabrics and leather for antibacterial activity. J. Photochem. Photobiol. B 2016, 160, 102–109. [Google Scholar] [CrossRef]
- Kate, S.; Sahasrabudhe, M.; Pethe, A. Biogenic Silver Nanoparticle Synthesis, Characterization and its Antibacterial activity against Leather Deteriorates. Jordan J. Biol. Sci. 2020, 13, 493–498. [Google Scholar]
- Rohaeti, E.; Kasmudjiastuti, E.; Murti, R.; Dodi, I. Enhancement of antibacterial activity of suede leather through coating silver nanoparticles synthesized using piper betle. Rasayan J. Chem. 2020, 13, 628–635. [Google Scholar] [CrossRef]
- Abdelghany, T.M.; Al-Rajhi, A.M.H.; Al Abboud, M.A.; Alawlaqi, M.M.; Ganash Magdah, A.; Helmy, E.A.M.; Mabrouk, A.S. Recent Advances in Green Synthesis of Silver Nanoparticles and Their Applications: About Future Directions. A Review. BioNanoScience 2018, 8, 5–16. [Google Scholar] [CrossRef]
- Sharma, V.K.; Yngard, R.A.; Lin, Y. Silver nanoparticles: Green synthesis and their antimicrobial activities. Adv. Colloid Interface Sci. 2009, 145, 83–96. [Google Scholar] [CrossRef]
- Thi Lan Huong, V.; Nguyen, N.T. Green synthesis, characterization and antibacterial activity of silver nanoparticles using Sapindus mukorossi fruit pericarp extract. Mater. Today Proc. 2021, 42, 88–93. [Google Scholar] [CrossRef]
- Ahmad, S.; Munir, S.; Zeb, N.; Ullah, A.; Khan, B.; Ali, J.; Bilal, M.; Omer, M.; Alamzeb, M.; Salman, S.M.; et al. Green nanotechnology: A review on green synthesis of silver nanoparticles—An ecofriendly approach. Int. J. Nanomed. 2019, 14, 5087–5107. [Google Scholar] [CrossRef]
- Jadoun, S.; Arif, R.; Jangid, N.K.; Meena, R.K. Green synthesis of nanoparticles using plant extracts: A review. Environ. Chem. Lett. 2021, 19, 355–374. [Google Scholar] [CrossRef]
- Nguyen, N.-T.; Vo, T.-L.-H. Fabrication of Silver Nanoparticles Using Cordyline fruticosa L. Leave Extract Endowing Silk Fibroin Modified Viscose Fabric with Durable Antibacterial Property. Polymers 2022, 14, 2409. [Google Scholar] [CrossRef] [PubMed]
- Gour, A.; Jain, N.K. Advances in green synthesis of nanoparticles. Artif. Cells Nanomed., Biotechnol. 2019, 47, 844–851. [Google Scholar] [CrossRef]
- Sharma, D.; Kanchi, S.; Bisetty, K. Biogenic synthesis of nanoparticles: A review. Arabian J. Chem. 2019, 12, 3576–3600. [Google Scholar] [CrossRef]
- Vu, T.H.; Bui, V.H.; Nguyen, N.T. Antibacterial Properties of Silver Nanoparticles Synthesized Using Piper betle L. Leaf Extract. Mater. Sci. Forum 2021, 1020, 236–242. [Google Scholar] [CrossRef]
- ISO 20882:2007; Footwear—Performance Requirements for Components for Footwear—Lining and Insocks. ISO: Geneva, Switzerland, 2007.
- The Clinical and Laboratory Standards Institute (CLSI). Approved Standard M7-A7; Methods for Dilution Antimicrobial Susceptibility Tests for Bacteria that Grow Aerobically; The Clinical and Laboratory Standards Institute (CLSI): Wayne, PA, USA, 2006; Volume 26. [Google Scholar]
- AATCC TM90; Test Method for Antibacterial Activity of Textile Materials: Agar Plate. AATCC: Research Triangle Park, NC, USA, 2016.
- AATCC TM30; Test Method for Antifungal Activity, Assessment on Textile Materials: Mildew and Rot Resistance of Textile Materials. AATCC: Research Triangle Park, NC, USA, 2017.
- ISO 16187:2013; Footwear and Footwear Components—Test Method to Assess Antibacterial Activity. ISO: Genewa, Switzerland, 2013.
- Vijay, R.; Drisya, V.M.; Selta, D.R.F.; Rathi, M.A.; Gopalakrishnan, V.K.; Alkhalifah, D.H.M.; Hozzein, W.N. Synthesis and characterization of silver nanomaterial from aqueous extract of Commelina forskaolii and its potential antimicrobial activity against Gram negative pathogens. J. King Saud Univ. Sci. 2023, 35, 102373. [Google Scholar] [CrossRef]
- Biswas, A.; Vanlalveni, C.; Adhikari, P.P.; Lalfakzuala, R.; Rokhum, L. Green biosynthesis, characterisation and antimicrobial activities of silver nanoparticles using fruit extract of Solanum viarum. IET Nanobiotechnol. 2018, 12, 933–938. [Google Scholar] [CrossRef]
- Shaheen, T.I.; Abd El Aty, A.A. In-situ green myco-synthesis of silver nanoparticles onto cotton fabrics for broad spectrum antimicrobial activity. Int. J. Biol. Macromol. 2018, 118, 2121–2130. [Google Scholar] [CrossRef]
- Carvalho, I.; Lima, M.J.; Nobre, D.; Marques, S.M.; Castro, D.; Leite, T.R.; Henriques, M.; Duarte, F.; Ramalho, A.; Carvalho, S. Silver oxide coatings deposited on leathers to prevent diabetic foot infections. Surf. Coat. Technol. 2022, 442, 128338. [Google Scholar] [CrossRef]
- Zhang, X.; Wang, W.; Yu, D. Synthesis of waterborne polyurethane–silver nanoparticle antibacterial coating for synthetic leather. J. Coat. Technol. Res. 2018, 15, 415–423. [Google Scholar] [CrossRef]

| Sample | Wet Pickup (%) | AgPBL (μg/mL) | L* | a* | b* | ΔE* | Real Images |
|---|---|---|---|---|---|---|---|
| Le | - | - | 62.42 | 9.77 | 23.86 | 0 | ![]() |
| pLeAg11 | 70 | 160 | 57.94 | 9.13 | 21.38 | 2.33 | ![]() |
| pLeAg12 | 80 | 57.97 | 9.75 | 21.12 | 2.41 | ![]() | |
| pLeAg13 | 90 | 57.01 | 9.27 | 21.38 | 2.66 | ![]() | |
| pLeAg12 | 80 | 160 | 57.97 | 9.75 | 21.12 | 2.41 | ![]() |
| pLeAg22 | 80 | 59.85 | 9.29 | 22.27 | 1.39 | ![]() | |
| pLeAg32 | 40 | 59.94 | 9.79 | 23.07 | 1.15 | ![]() | |
| pLeAg42 | 20 | 60.01 | 9.54 | 23.74 | 1.04 | ![]() |
| Sample | Wet Pickup (%) | AgPBL (μg/mL) | Total Silver Content (mg/kg) |
|---|---|---|---|
| Le | - | - | 0 |
| pLeAg12 | 80 | 160 | 379.0 ± 4.6 |
| Sample | Wet Pickup (%) | AgPBL (µg/mL) | E. coli | S. aureus |
|---|---|---|---|---|
| Vis | - | - | 0 | 0 |
| Strep | - | - | 21.10 ± 1.10 | 29.00 ± 0.73 |
| pLeAg11 | 70 | 160 | 8.40 ± 0.37 | 9.60 ± 0.33 |
| pLeAg12 | 80 | 8.70 ± 0.21 | 10.20 ± 0.24 | |
| pLeAg13 | 90 | 8.20 ± 0.22 | 9.10 ± 0.36 | |
| Strep’ | - | - | 23.30 ± 0.92 | 24.00 ± 1.02 |
| pLeAg12 | 80 | 160 | 11.40 ± 1.10 | 8.40 ± 0.33 |
| pLeAg22 | 80 | 11.20 ± 0.24 | 7.30 ± 0.22 | |
| pLeAg32 | 40 | 10.50 ± 1.00 | 2.10 ± 0.08 | |
| pLeAg42 | 20 | 8.40 ± 0.37 | - |
| No | Properties | Unit | Le | pLeAg | ISO 20882:2007 Requirements |
|---|---|---|---|---|---|
| 1 | Tear strength (ISO 17696) | N | 32 | 32.5 | lining ≥ 15 N |
| Compare to the pristine leather (Le) | % | 100.0 | 101.6 | ||
| Compare to ISO 20882:2007 | % | 213.3 | 216.7 | ||
| 2 | Abrasion resistance (ISO 17704) | cycles | Without hole through the thickness of the material component | 25,600 cycles dry 12,800 cycles wet | |
| 3 | Flex resistance (ISO 17694) | cycles | 15,000 cycles dry without visible damage | Dry 15,000 cycles without visible damage | |
| 4 | Lining water vapour permeability (ISO 17699) | mg/cm2.h | 3.13 | 3.62 | WVP of lining ≥ 2.0 mg/cm2.h |
| Compare to the pristine leather (Le) | % | 100.0 | 115.7 | ||
| Compare to ISO 20882:2007 | % | 156.0 | 181.0 | ||
| 5 | Lining water vapour absorption (ISO 17699) | mg/cm2 | 21.0 | 20.8 | WVA of lining ≥ 8.0 mg/cm2 |
| Compare to the pristine leather (Le) | % | 100.0 | 99.0 | ||
| Compare to ISO 20882:2007 | % | 263.0 | 260.0 | ||
| 6 | Lining water absorption (ISO 22649) | mg/cm2 | 54.1 | 53.9 | absorption ≥ 70 mg/cm2 |
| Compare to the pristine leather (Le) | % | 100.0 | 99.6 | ||
| Compare to ISO 20882:2007 | % | 90.1 | 89.3 | ||
| 7 | Lining water desorption (ISO 22649) | % | 97.1 | 97.2 | desorption ≥ 60 % |
| Compare to the pristine leather (Le) | % | 100.0 | 100.1 | ||
| Compare to ISO 20882:2007 | % | 161.8 | 162 | ||
Disclaimer/Publisher’s Note: The statements, opinions and data contained in all publications are solely those of the individual author(s) and contributor(s) and not of MDPI and/or the editor(s). MDPI and/or the editor(s) disclaim responsibility for any injury to people or property resulting from any ideas, methods, instructions or products referred to in the content. |
© 2023 by the authors. Licensee MDPI, Basel, Switzerland. This article is an open access article distributed under the terms and conditions of the Creative Commons Attribution (CC BY) license (https://creativecommons.org/licenses/by/4.0/).
Share and Cite
Nguyen, N.-T.; Vu, T.-H.; Bui, V.-H. Antibacterial and Antifungal Fabrication of Natural Lining Leather Using Bio-Synthesized Silver Nanoparticles from Piper Betle L. Leaf Extract. Polymers 2023, 15, 2634. https://doi.org/10.3390/polym15122634
Nguyen N-T, Vu T-H, Bui V-H. Antibacterial and Antifungal Fabrication of Natural Lining Leather Using Bio-Synthesized Silver Nanoparticles from Piper Betle L. Leaf Extract. Polymers. 2023; 15(12):2634. https://doi.org/10.3390/polym15122634
Chicago/Turabian StyleNguyen, Ngoc-Thang, Tien-Hieu Vu, and Van-Huan Bui. 2023. "Antibacterial and Antifungal Fabrication of Natural Lining Leather Using Bio-Synthesized Silver Nanoparticles from Piper Betle L. Leaf Extract" Polymers 15, no. 12: 2634. https://doi.org/10.3390/polym15122634
APA StyleNguyen, N.-T., Vu, T.-H., & Bui, V.-H. (2023). Antibacterial and Antifungal Fabrication of Natural Lining Leather Using Bio-Synthesized Silver Nanoparticles from Piper Betle L. Leaf Extract. Polymers, 15(12), 2634. https://doi.org/10.3390/polym15122634









